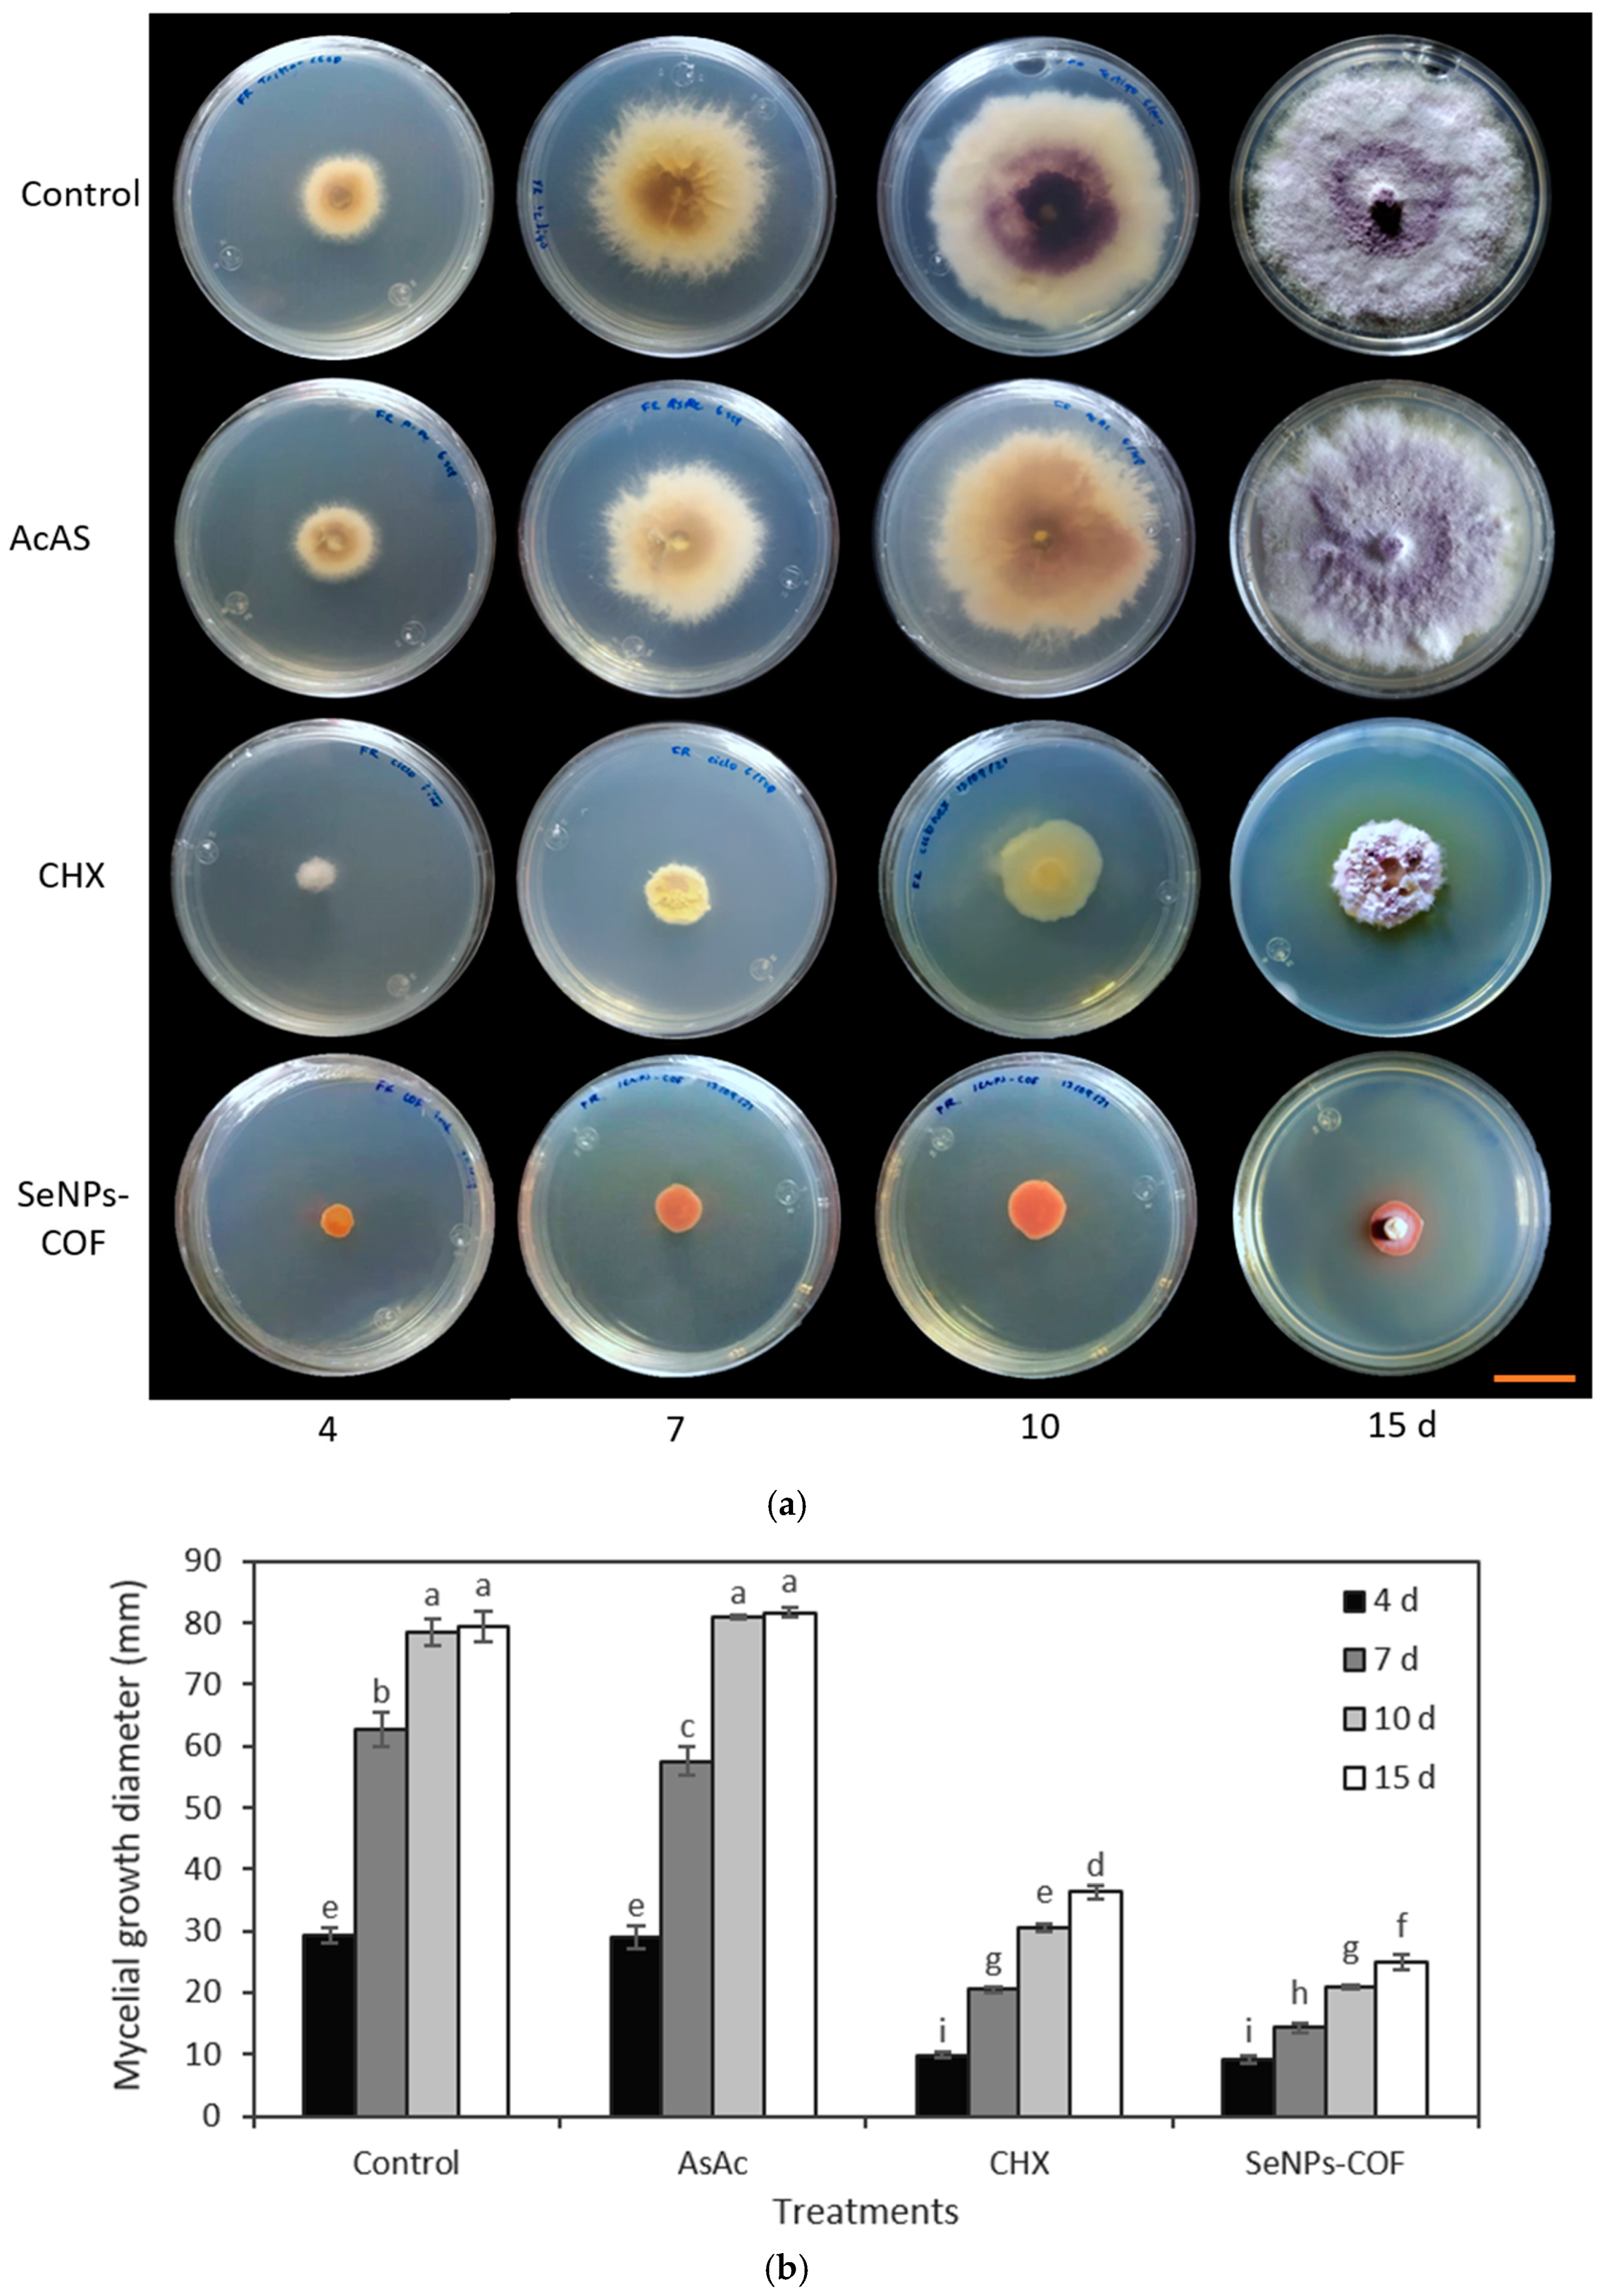
Antibiotics 12 00115 g006 Antibiotics 12 00115 g006
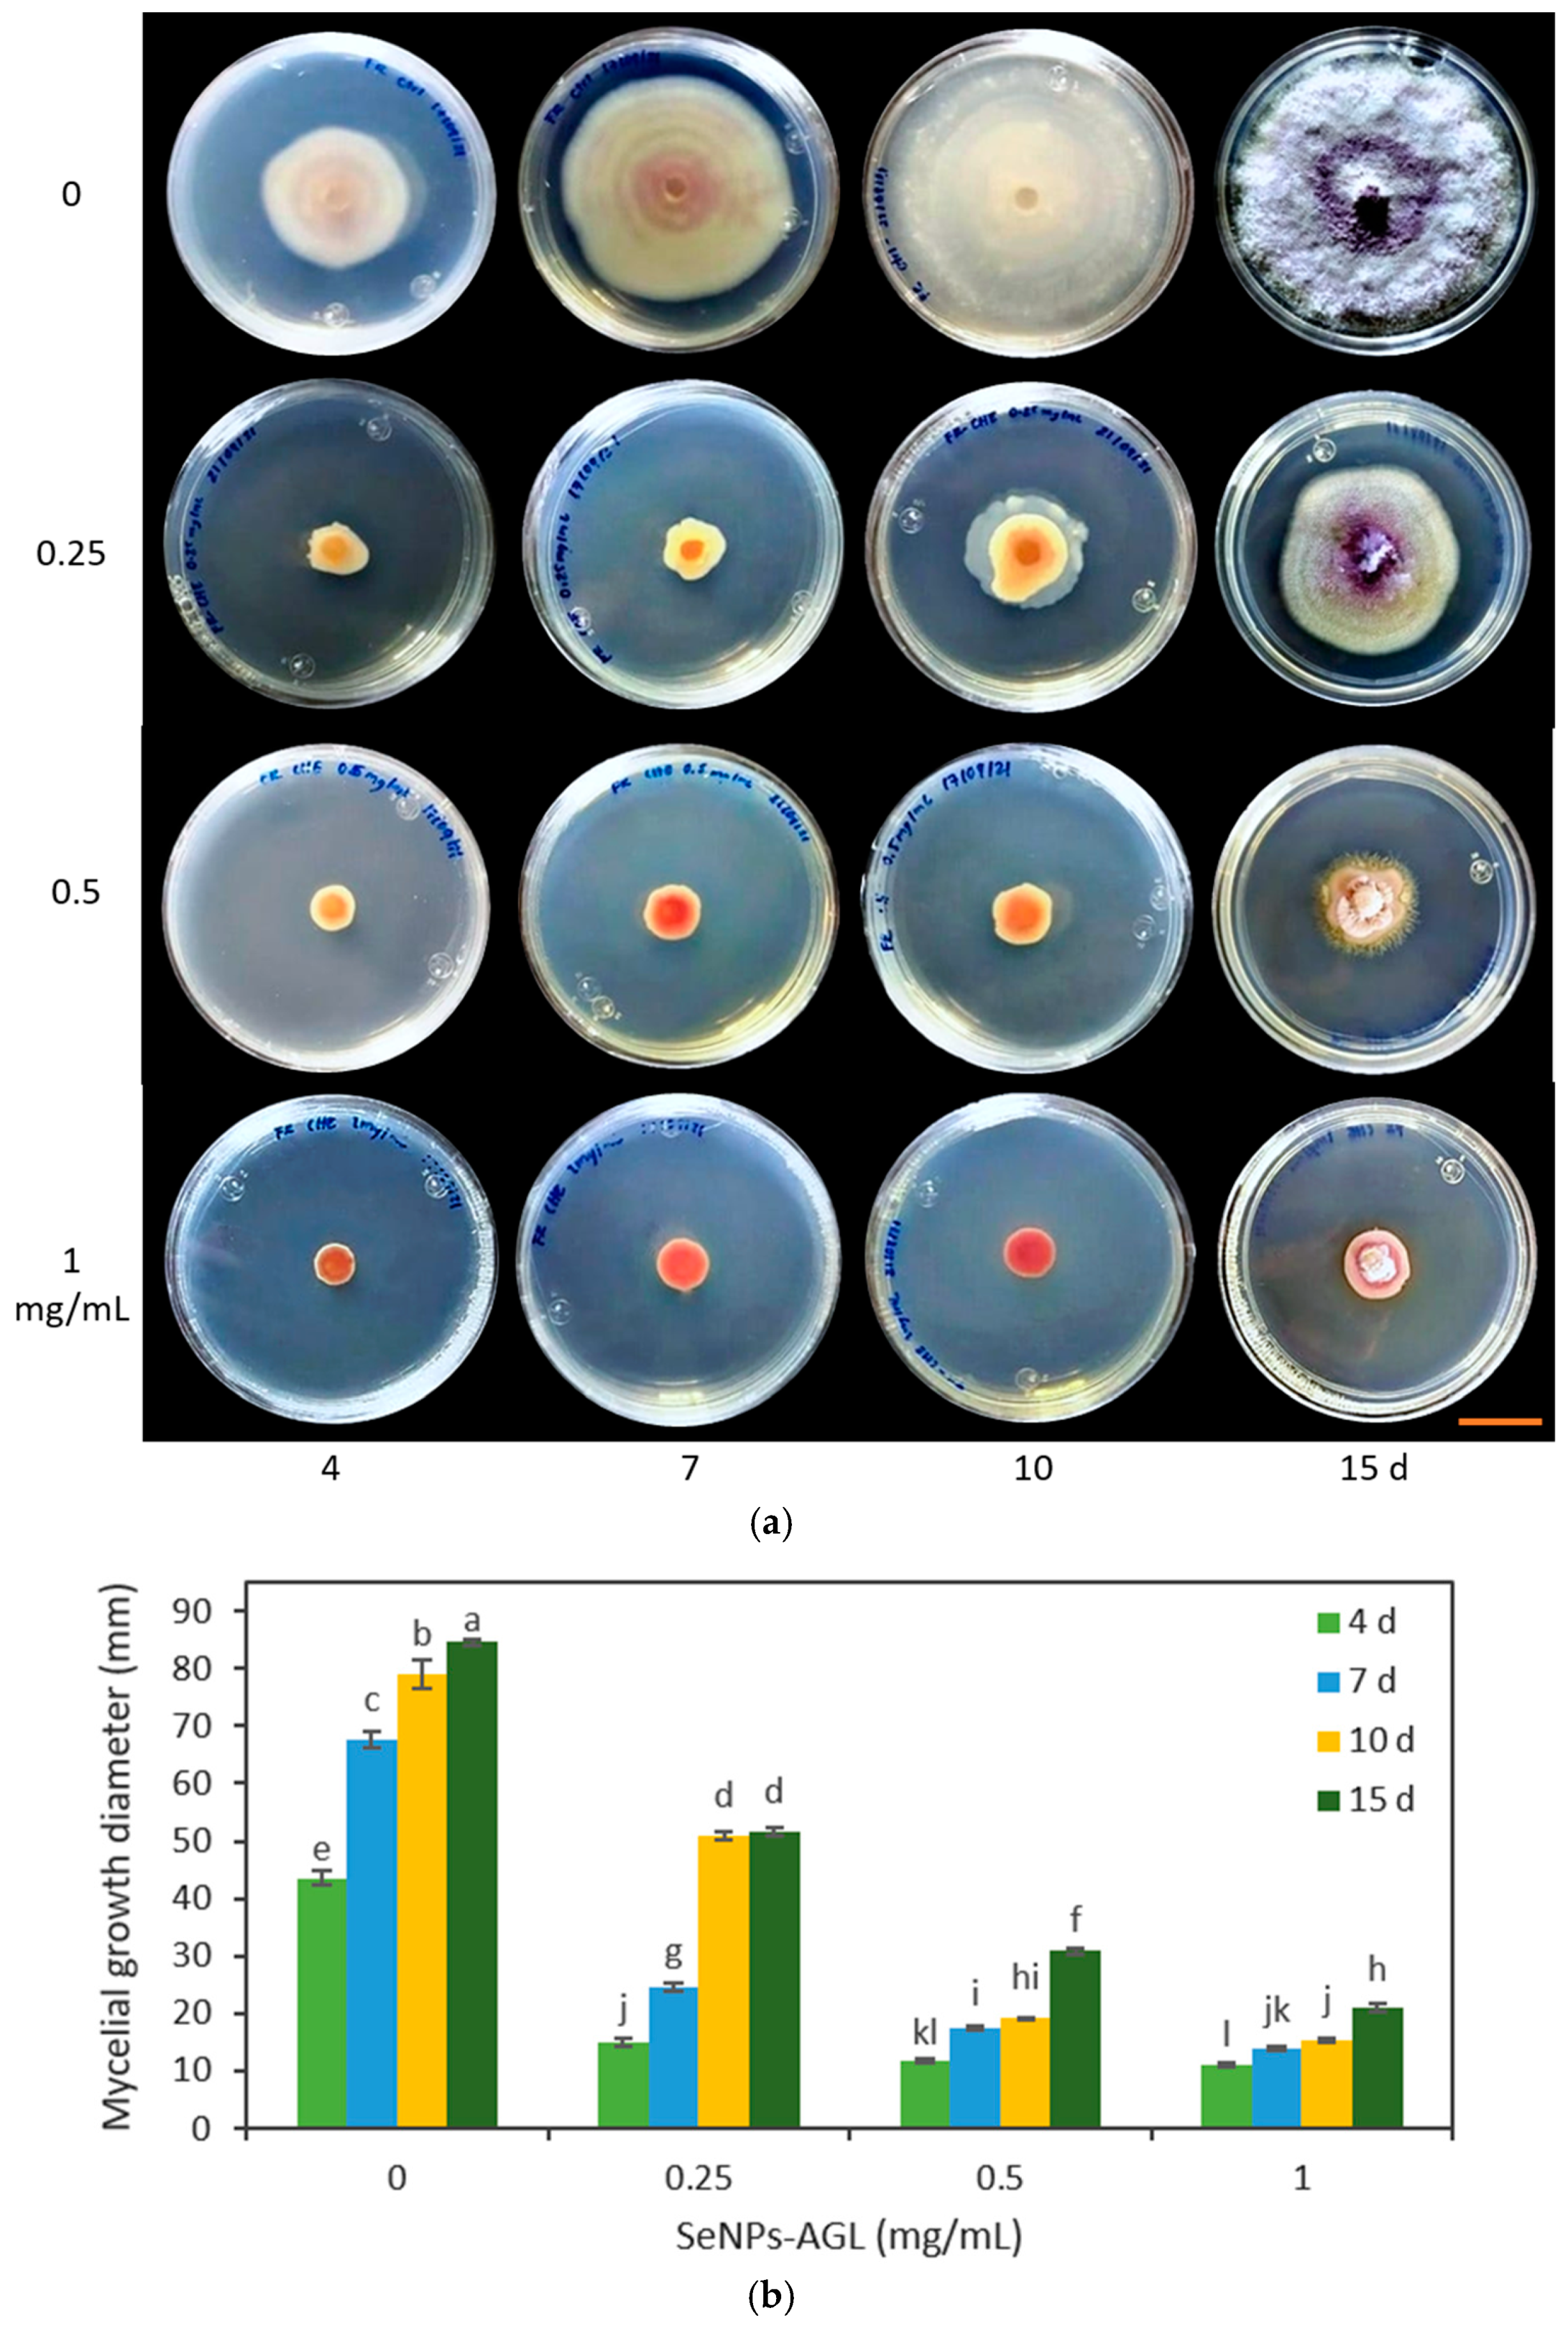
Antibiotics 12 00115 g008 Antibiotics 12 00115 g008
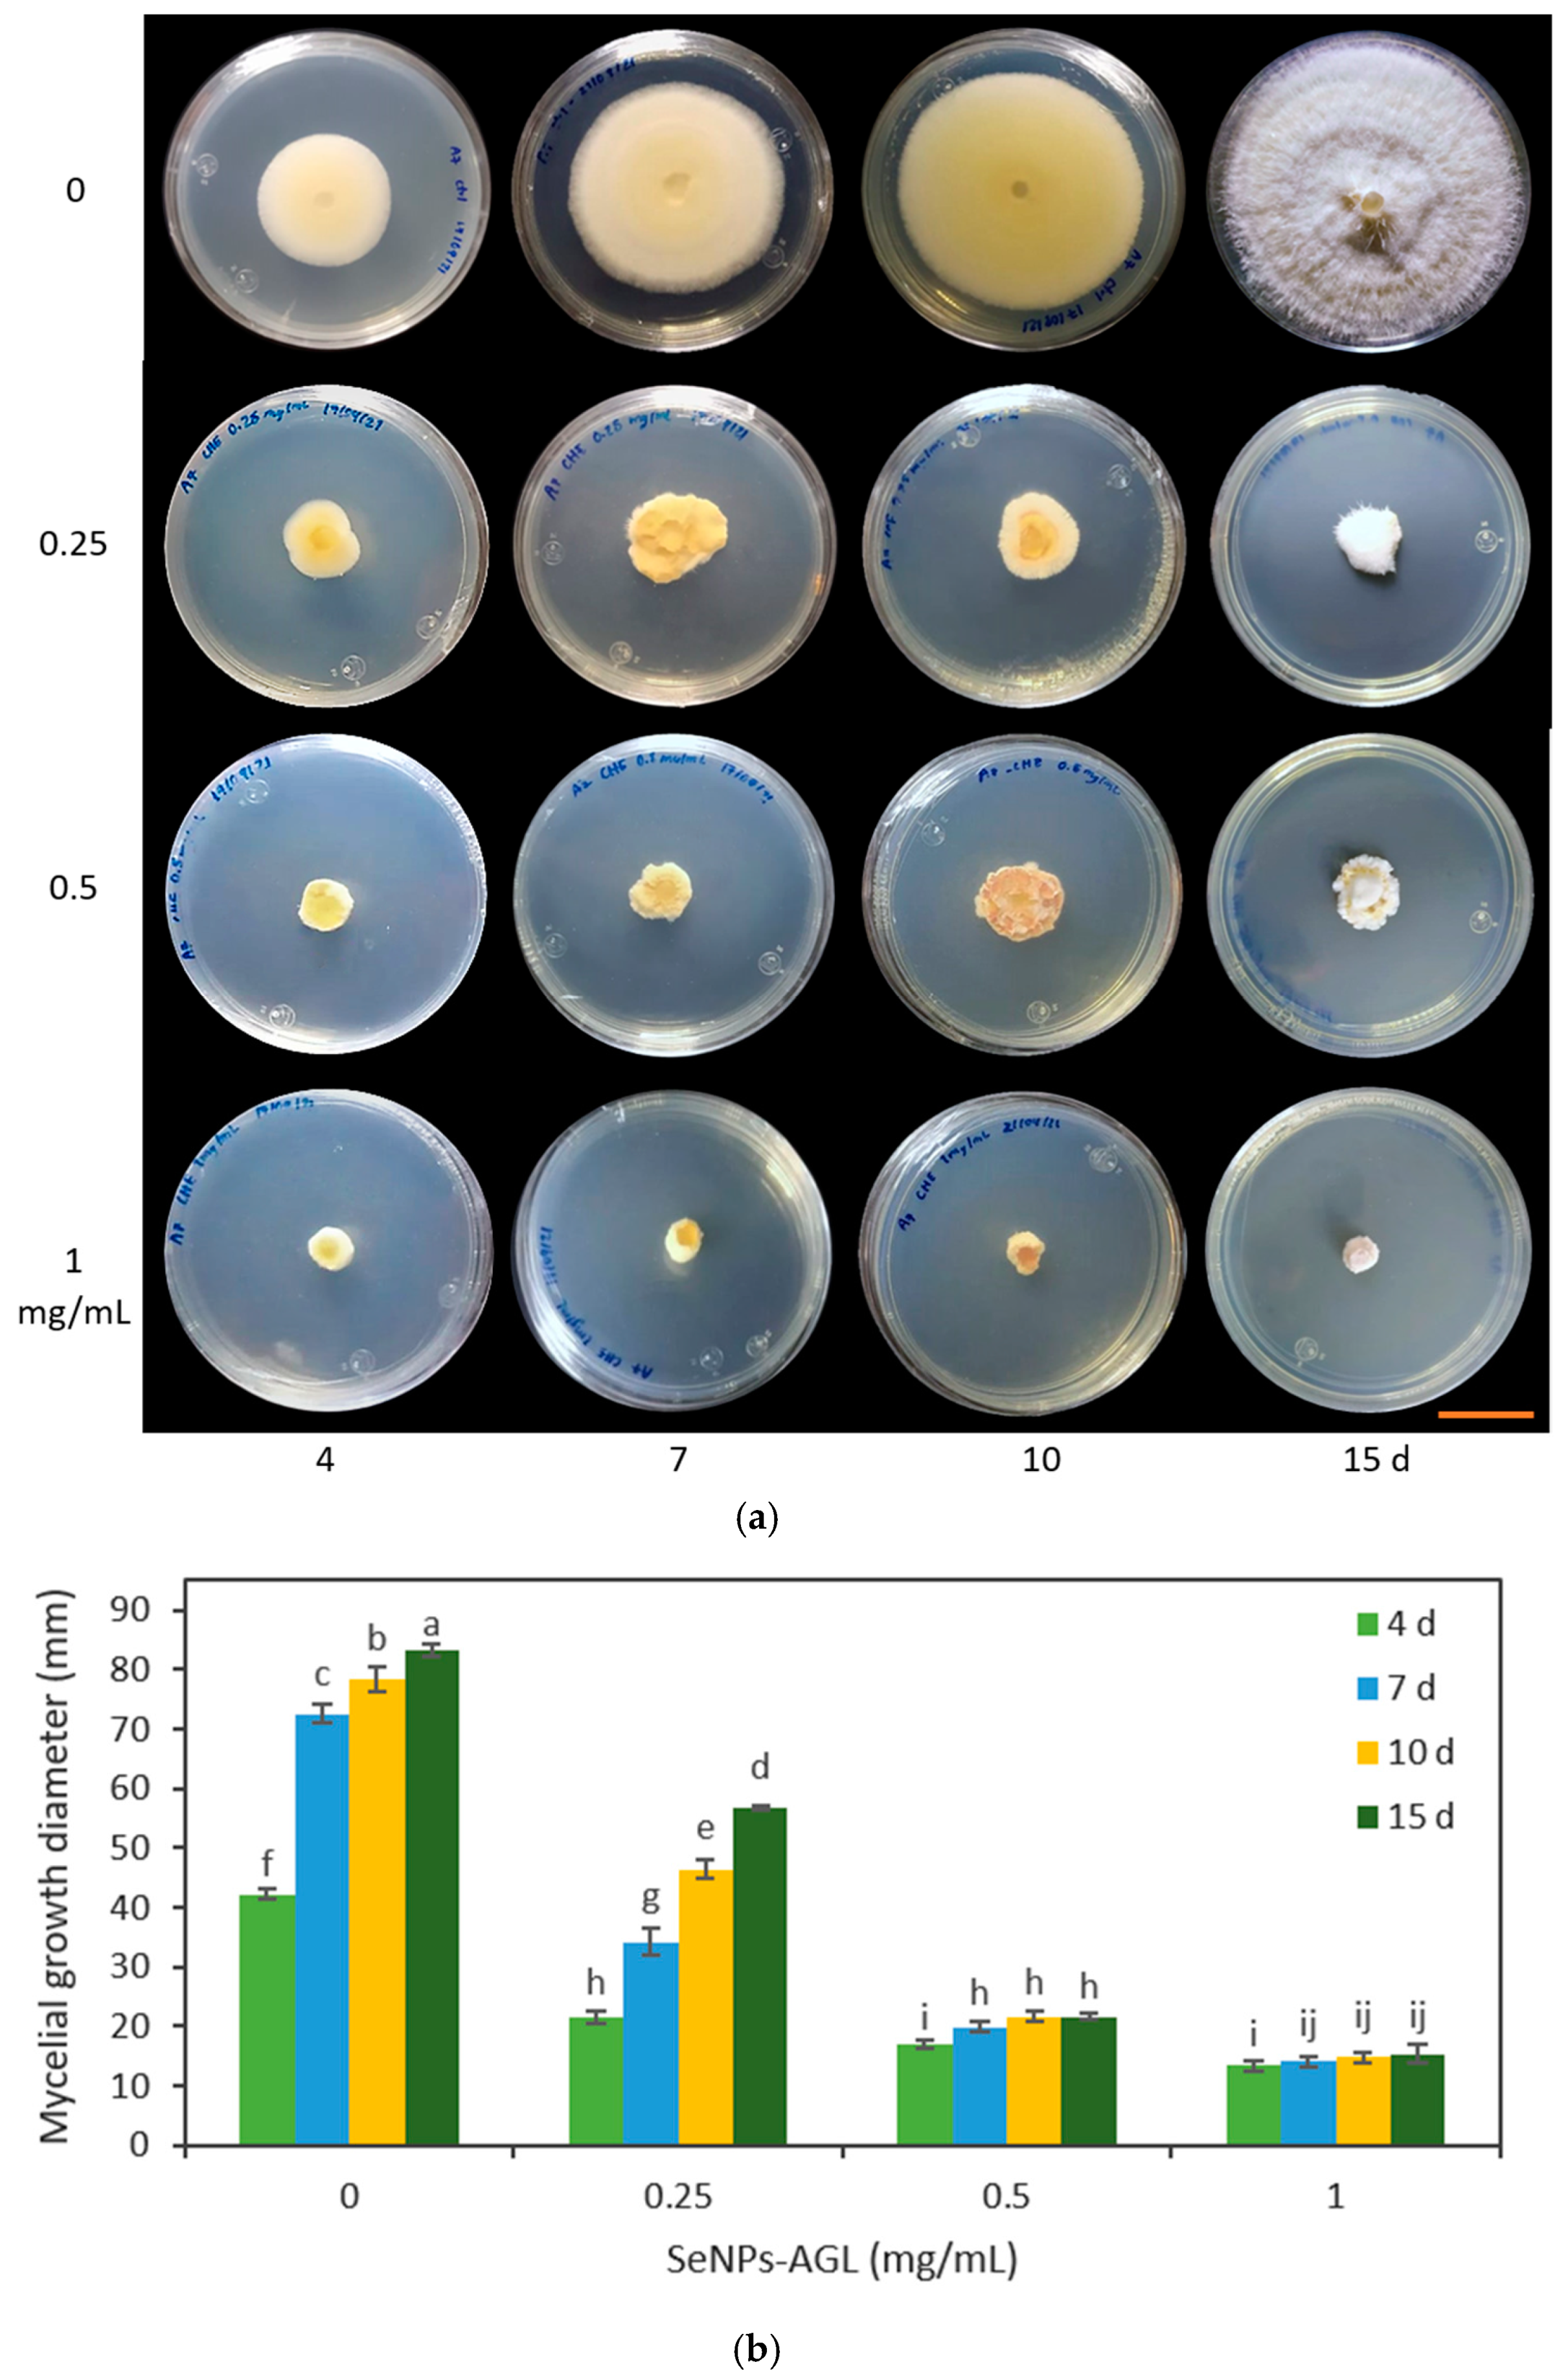
Antibiotics 12 00115 g010 Antibiotics 12 00115 g010
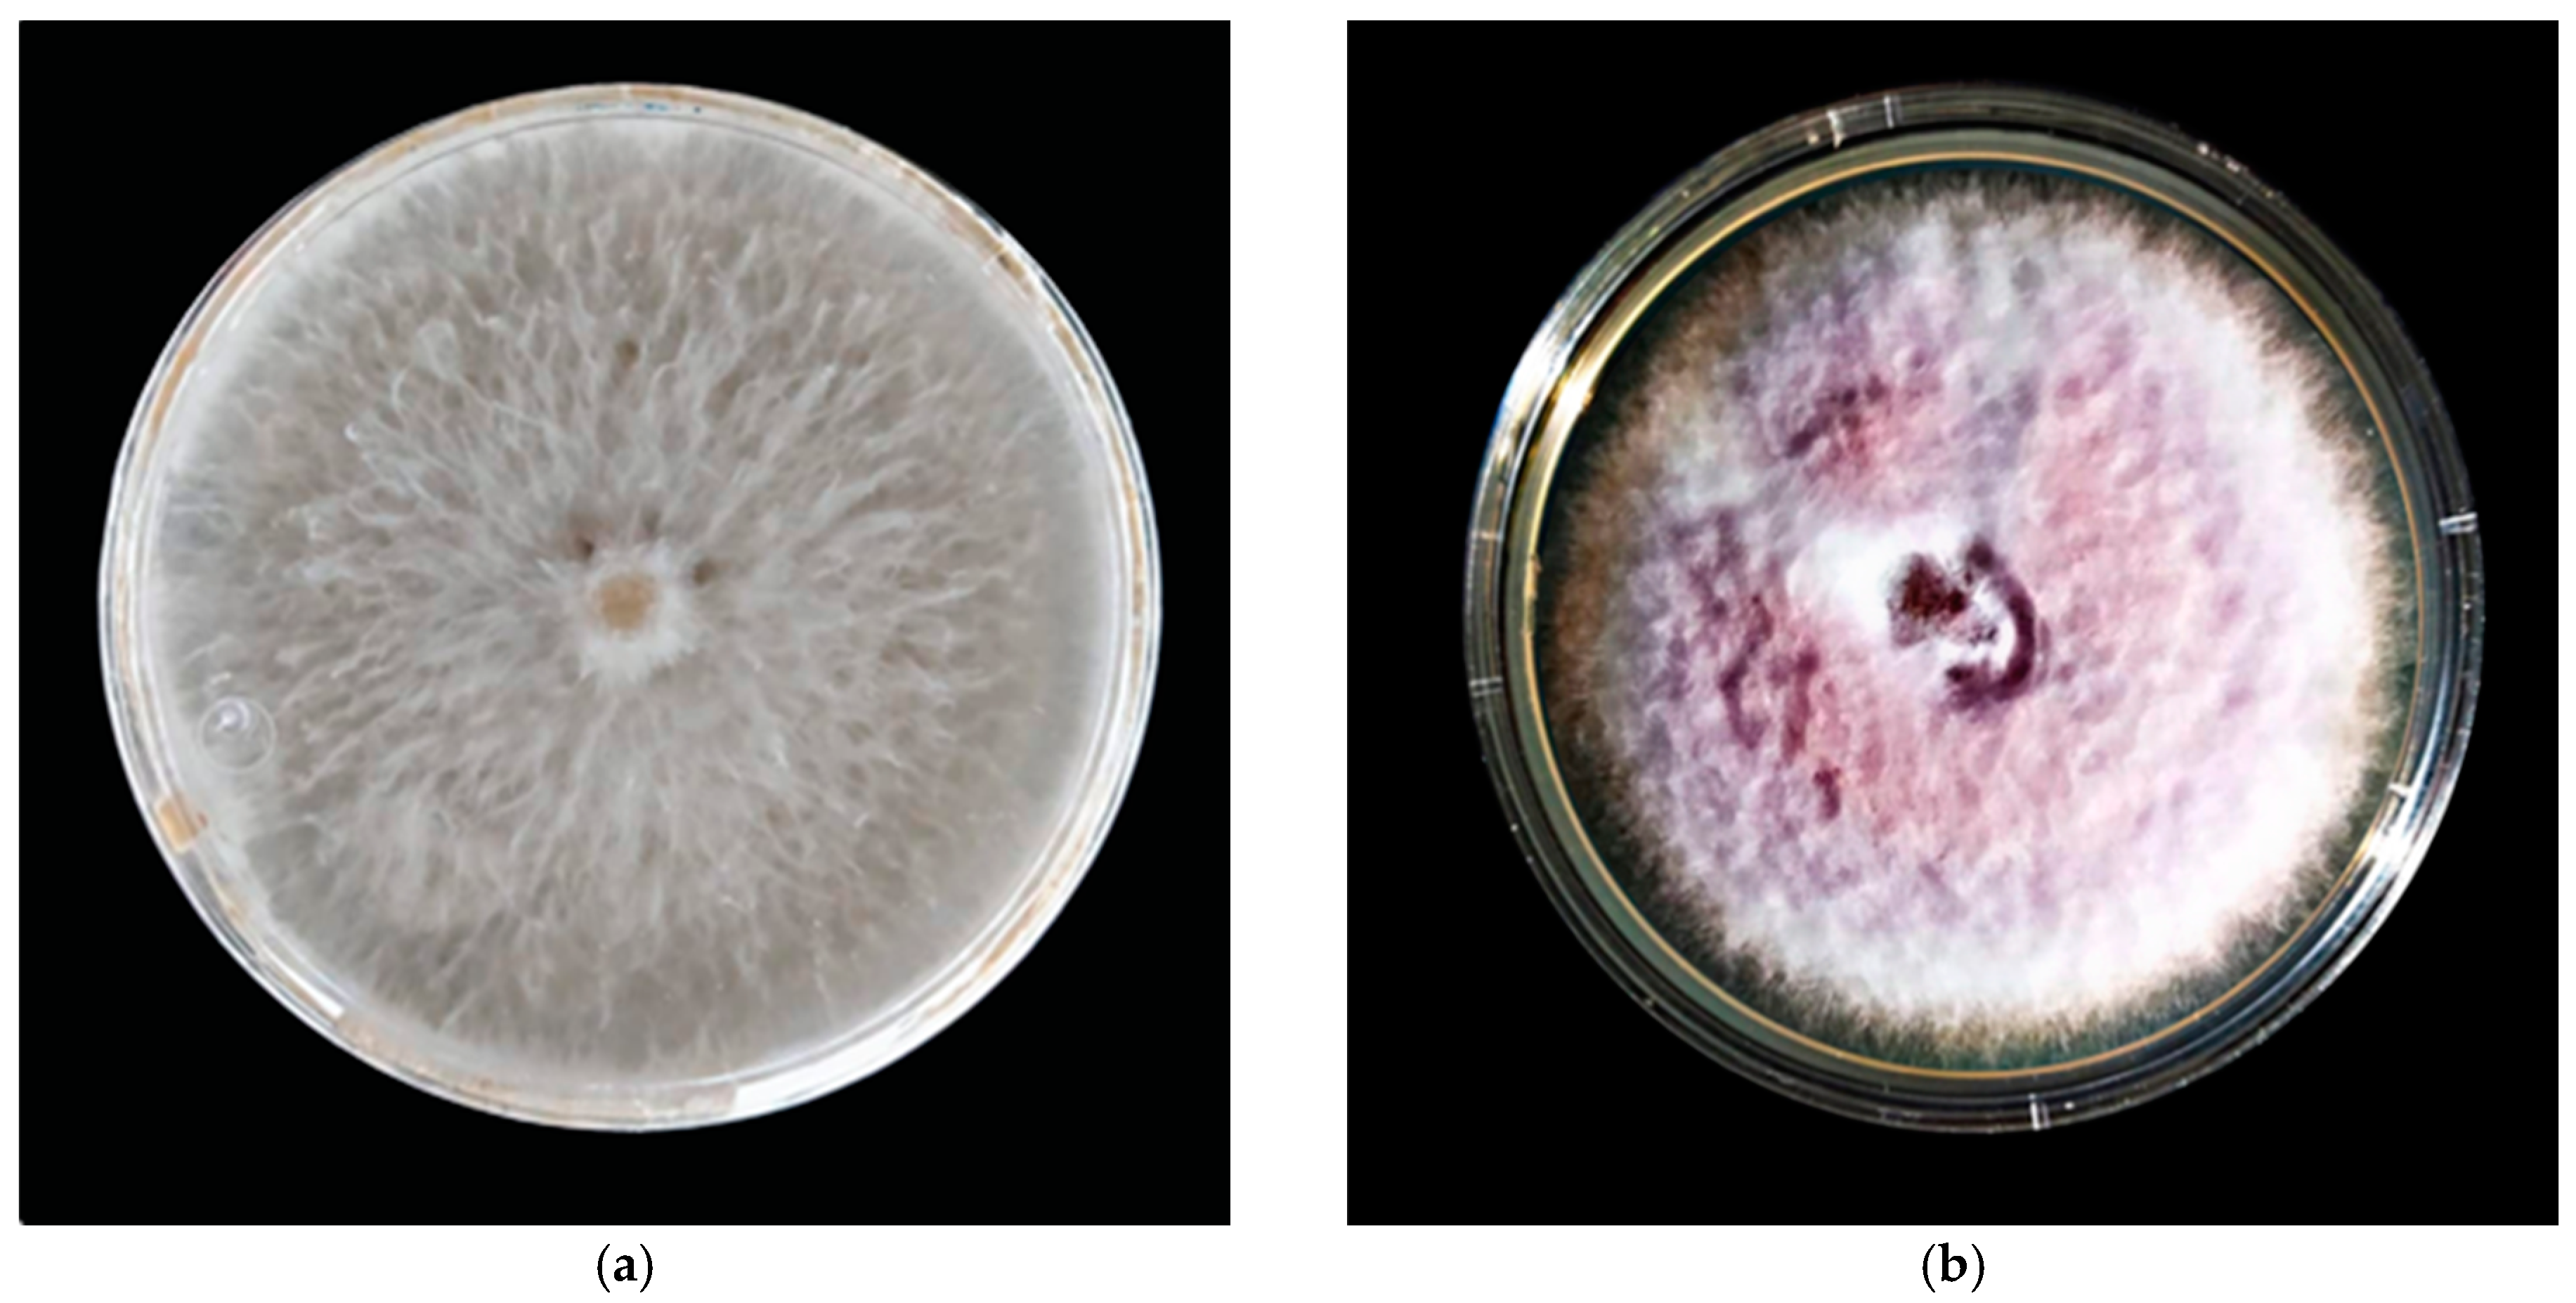
Antibiotics 12 00115 g012 Antibiotics 12 00115 g012

Antifungal Activity of Selenium Nanoparticles Obtained by Plant-Mediated Synthesis
Abstract
1. Introduction
2. Results
2.1. Antimicrobial Activity of Plant Extracts
2.2. SeNP Size
2.3. FTIR Analysis of SeNPs
2.4. Elemental Composition of SeNPs
2.5. Antifungal Activity of SeNPs
2.6. Effect of SeNP Concentration
3. Discussion
4. Materials and Methods
4.1. Plant Material
4.2. Preparation of the Extract
4.3. Evaluation of the Antimicrobial Activity of Plant Extracts
4.4. SeNPs Synthesis
4.5. Determination of the Size of the Nanoparticles
4.6. Fourier Transform Infrared Spectroscopy (FTIR) Analysis of SeNPs
4.7. Determination of the Elemental Composition of NPs
4.8. Fungal Strains
4.9. Evaluation of the Antifungal Activity of SeNPs
4.10. Statistic Analysis
5. Conclusions
6. Patents
Author Contributions
Funding
Institutional Review Board Statement
Informed Consent Statement
Data Availability Statement
Acknowledgments
Conflicts of Interest
References
- Sumner, S.E.; Markley, R.L.; Kirimanjeswara, G.S. Role of Selenoproteins in Bacterial Pathogenesis. Biol. Trace Elem. Res. 2019, 192, 69–82. [Google Scholar] [CrossRef]
- Garza-García, J.J.O.; Hernández-Díaz, J.A.; Zamudio-Ojeda, A.; León-Morales, J.M.; Guerrero-Guzmán, A.; Sánchez-Chiprés, D.R.; López-Velázquez, J.C.; García-Morales, S. The Role of Selenium Nanoparticles in Agriculture and Food Technology. Biol. Trace Elem. Res. 2022, 200, 2528–2548. [Google Scholar] [CrossRef] [PubMed]
- Breydo, L. Selenium, Biologically Active Compounds. In Encyclopedia of Metalloproteins; Kretsinger, R.H., Uversky, V.N., Permyakov, E.A., Eds.; Springer: New York, NY, USA, 2013; pp. 1919–1924. [Google Scholar] [CrossRef]
- Hanson, B.; Garifullina, G.F.; Lindblom, S.D.; Wangeline, A.; Ackley, A.; Kramer, K.; Norton, A.P.; Lawrence, C.B.; Pilon-Smits, E.A.H. Selenium Accumulation protects Brassica juncea from invertebrate herbivory and fungal infection. New Phytol. 2003, 159, 461–469. [Google Scholar] [CrossRef]
- Alam, M.F.; Safhi, M.M.; Moni, S.S.; Jabeen, A. In Vitro Antibacterial Spectrum of Sodium Selenite against Selected Human Pathogenic Bacterial Strains. Scientifica 2016, 2016, 9176273. [Google Scholar] [CrossRef] [PubMed]
- Sadeghian, S.; Kojouri, G.A.; Mohebbi, A. Nanoparticles of Selenium as Species with Stronger Physiological Effects in Sheep in Comparison with Sodium Selenite. Biol. Trace Elem. Res. 2012, 146, 302–308. [Google Scholar] [CrossRef] [PubMed]
- Gautam, P.K.; Kumar, S.; Tomar, M.S.; Singh, R.K.; Acharya, A.; Kumar, S.; Ram, B. Selenium nanoparticles induce suppressed function of tumor associated macrophages and inhibit Dalton’s lymphoma proliferation. Biochem. Biophys. Rep. 2017, 12, 172–184. [Google Scholar] [CrossRef]
- Kora, A.J. Tree gum stabilised selenium nanoparticles: Characterisation and antioxidant activity. IET Nanobiotechnology 2018, 12, 658–662. [Google Scholar] [CrossRef]
- Shahabadi, N.; Zendehcheshm, S.; Khademi, F. Selenium nanoparticles: Synthesis, in-vitro cytotoxicity, antioxidant activity and interaction studies with Ct-DNA and HSA, HHb and Cyt c Serum Proteins. Biotechnol. Rep. 2021, 30, e00615. [Google Scholar] [CrossRef]
- Wadhwani, S.A.; Shedbalkar, U.U.; Singh, R.; Chopade, B.A. Biogenic selenium nanoparticles: Current status and future prospects. Appl. Microbiol. Biotechnol. 2016, 100, 2555–2566. [Google Scholar] [CrossRef]
- Teoh, E.S. Secondary Metabolites of Plants. In Medicinal Orchids of Asia; Teoh, E.S., Ed.; Springer: Cham, Switzerland; Singapore, 2016; pp. 59–73. [Google Scholar] [CrossRef]
- Marslin, G.; Siram, K.; Maqbool, Q.; Selvakesavan, R.; Kruszka, D.; Kachlicki, P.; Franklin, G. Secondary Metabolites in the Green Synthesis of Metallic Nanoparticles. Materials 2018, 11, 940. [Google Scholar] [CrossRef]
- El-Kemary, M. Calendula officinalis-mediated biosynthesis of Silver Nanoparticles and Their Electrochemical and Optical Characterization. Int. J. Electrochem. Sci. 2016, 10795–10805. [Google Scholar] [CrossRef]
- Hernández-Díaz, J.A.; Garza-García, J.J.O.; Zamudio-Ojeda, A.; León-Morales, J.M.; López-Velázquez, J.C.; García-Morales, S. Plant-mediated synthesis of nanoparticles and their antimicrobial activity against phytopathogens. J. Sci. Food Agric. 2021, 101, 1270–1287. [Google Scholar] [CrossRef] [PubMed]
- Sharma, G.; Sharma, A.; Bhavesh, R.; Park, J.; Ganbold, B.; Nam, J.-S.; Lee, S.-S. Biomolecule-mediated synthesis of selenium nanoparticles using dried Vitis Vinifera (Raisin) Extract. Molecules 2014, 19, 2761–2770. [Google Scholar] [CrossRef] [PubMed]
- Cittrarasu, V.; Kaliannan, D.; Dharman, K.; Maluventhen, V.; Easwaran, M.; Liu, W.C.; Balasubramanian, B.; Arumugam, M. Green synthesis of selenium nanoparticles mediated from Ceropegia bulbosa Roxb extract and its cytotoxicity, antimicrobial, mosquitocidal and photocatalytic activities. Sci. Rep. 2021, 11, 1032. [Google Scholar] [CrossRef] [PubMed]
- Dang-Bao, T.; Ho, T.G.-T.; Do, B.L.; Phung Anh, N.; Phan, T.D.T.; Tran, T.B.Y.; Duong, N.L.; Hong Phuong, P.; Nguyen, T. Green Orange Peel-Mediated Bioinspired Synthesis of Nanoselenium and Its Antibacterial Activity against Methicillin-Resistant Staphylococcus aureus. ACS Omega 2022, 7, 36037–36046. [Google Scholar] [CrossRef] [PubMed]
- Jha, N.; Esakkiraj, P.; Annamalai, A.; Lakra, A.K.; Naik, S.; Arul, V. Synthesis, Optimization, and Physicochemical Characterization of Selenium Nanoparticles from Polysaccharide of Mangrove Rhizophora mucronata with Potential Bioactivities. J. Trace Elem. Miner. 2022, 2, 100019. [Google Scholar] [CrossRef]
- Shubharani, R.; Mahesh, M.; Yogananda Murthy, V.N. Biosynthesis and Characterization, Antioxidant and Antimicrobial Activities of Selenium Nanoparticles from Ethanol Extract of Bee Propolis. J. Nanomed. Nanotechnol. 2019, 10, 522. [Google Scholar] [CrossRef]
- Gudkov, S.V.; Shafeev, G.A.; Glinushkin, A.P.; Shkirin, A.V.; Barmina, E.V.; Rakov, I.I.; Simakin, A.V.; Kislov, A.V.; Astashev, M.E.; Vodeneev, V.A.; et al. Production and Use of Selenium Nanoparticles as Fertilizers. ACS Omega 2020, 5, 17767–17774. [Google Scholar] [CrossRef]
- Sampaio, A.M.; Araújo, S.d.S.; Rubiales, D.; Vaz Patto, M.C. Fusarium Wilt Management in Legume Crops. Agronomy 2020, 10, 1073. [Google Scholar] [CrossRef]
- Zakaria, L. Diversity of Colletotrichum Species Associated with Anthracnose Disease in Tropical Fruit Crops—A Review. Agriculture 2021, 11, 297. [Google Scholar] [CrossRef]
- Garza-García, J.J.O.; Hernández-Díaz, J.A.; León-Morales, J.M.; Zamudio-Ojeda, A.; Arratia-Quijada, J.; Reyes-Maldonado, O.K.; Velázquez-Juárez, G.; López-Velázquez, J.C.; García-Morales, S. Antibacterial properties, antioxidant activity, and plant biostimulant effects of selenium nanoparticles based on plant extracts. Ann. Agric. Sci. 2022; submitted. [Google Scholar]
- Hernández-Díaz, J.A.; Garza-García, J.J.; León-Morales, J.M.; Zamudio-Ojeda, A.; Arratia-Quijada, J.; Velázquez-Juárez, G.; López-Velázquez, J.C.; García-Morales, S. Antibacterial Activity of Biosynthesized Selenium Nanoparticles Using Extracts of Calendula officinalis against Potentially Clinical Bacterial Strains. Molecules 2021, 26, 5929. [Google Scholar] [CrossRef] [PubMed]
- Gazim, Z.C.; Rezende, C.M.; Fraga, S.R.; Svidzinski, T.I.E.; Cortez, D.A.G. Antifungal activity of the essential oil from Calendula officinalis L. (Asteraceae) growing in Brazil. Braz. J. Microbiol. 2008, 39, 61–63. [Google Scholar] [CrossRef] [PubMed]
- Sotelo-Barrera, M.; Cília-García, M.; Luna-Cavazos, M.; Díaz-Núñez, J.L.; Romero-Manzanares, A.; Soto-Hernández, R.M.; Castillo-Juárez, I. Amphipterygium adstringens (Schltdl.) Schiede Ex Standl (Anacardiaceae): An Endemic Plant with Relevant Pharmacological Properties. Plants 2022, 11, 1766. [Google Scholar] [CrossRef]
- Rodríguez-Luis, O.E.; Hernandez-Delgadillo, R.; Sánchez-Nájera, R.I.; Martínez-Castañón, G.A.; Niño-Martínez, N.; Sánchez Navarro, M.d.C.; Ruiz, F.; Cabral-Romero, C. Green Synthesis of Silver Nanoparticles and Their Bactericidal and Antimycotic Activities against Oral Microbes. J. Nanomater. 2016, 9204573. [Google Scholar] [CrossRef]
- Abdelwahab, S.I.; Taha, M.M.E.; Taha, S.M.E.; Alsayegh, A.A. Fifty-Year of Global Research in Calendula Officinalis L. (1971−2021): A Bibliometric Study. Clin. Complement. Med. Pharmacol. 2022, 2, 100059. [Google Scholar] [CrossRef]
- Ak, G.; Zengin, G.; Sinan, K.I.; Mahomoodally, M.F.; Picot-Allain, M.C.N.; Cakır, O.; Bensari, S.; Yılmaz, M.A.; Gallo, M.; Montesano, D. A Comparative Bio-Evaluation and Chemical Profiles of Calendula officinalis L. Extracts Prepared via Different Extraction Techniques. Appl. Sci. 2020, 10, 5920. [Google Scholar] [CrossRef]
- Miranda, A.; Akpobolokemi, T.; Chung, E.; Ren, G.; Raimi-Abraham, B.T. PH Alteration in Plant-Mediated Green Synthesis and Its Resultant Impact on Antimicrobial Properties of Silver Nanoparticles (AgNPs). Antibiotics 2022, 11, 1592. [Google Scholar] [CrossRef]
- Fissan, H.; Ristig, S.; Kaminski, H.; Asbach, C.; Epple, M. Comparison of Different Characterization Methods for Nanoparticle Dispersions before and after Aerosolization. Anal. Methods 2014, 6, 7324. [Google Scholar] [CrossRef]
- Huang, T.; Holden, J.A.; Heath, D.E.; O’Brien-Simpson, N.M.; O’Connor, A.J. Engineering highly effective antimicrobial selenium nanoparticles through control of particle size. Nanoscale 2019, 11, 14937–14951. [Google Scholar] [CrossRef]
- Mecozzi, M.; Sturchio, E. Computer Assisted Examination of Infrared and Near Infrared Spectra to Assess Structural and Molecular Changes in Biological Samples Exposed to Pollutants: A Case of Study. J. Imaging 2017, 3, 11. [Google Scholar] [CrossRef]
- Salomoni, R.; Léo, P.; Montemor, A.; Rinaldi, B.; Rodrigues, M. Antibacterial effect of silver nanoparticles in Pseudomonas aeruginosa. Nanotechnol. Sci. Appl. 2017, 10, 115–121. [Google Scholar] [CrossRef]
- Li, W.-R.; Xie, X.-B.; Shi, Q.-S.; Zeng, H.-Y.; OU-Yang, Y.-S.; Chen, Y.-B. Antibacterial activity and mechanism of silver nanoparticles on Escherichia coli. Appl. Microbiol. Biotechnol. 2010, 85, 1115–1122. [Google Scholar] [CrossRef] [PubMed]
- Lara, H.H.; Romero-Urbina, D.G.; Pierce, C.; Lopez-Ribot, J.L.; Arellano-Jiménez, M.J.; Jose-Yacaman, M. Effect of silver nanoparticles on Candida albicans biofilms: An ultrastructural study. J. Nanobiotechnol. 2015, 13, 91. [Google Scholar] [CrossRef]
- El-Saadony, M.T.; Saad, A.M.; Najjar, A.A.; Alzahrani, S.O.; Alkhatib, F.M.; Shafi, M.E.; Selem, E.; Desoky, E.-S.M.; Fouda, S.E.E.; El-Tahan, A.M.; et al. The use of biological Selenium nanoparticles to suppress Triticum aestivum L. crown and root rot diseases induced by fusarium species and improve yield under drought and heat stress. Saudi J. Biol. Sci. 2021, 28, 4461–4471. [Google Scholar] [CrossRef] [PubMed]
- Joshi, S.; De Britto, S.; Jogaiah, S.; Ito, S. Mycogenic Selenium Nanoparticles as Potential New Generation Broad Spectrum Antifungal Molecules. Biomolecules 2019, 9, 419. [Google Scholar] [CrossRef] [PubMed]
- Georgiou, C.D.; Petropoulou, K.P. Effect of the antioxidant ascorbic acid on sclerotial differentiation in Rhizoctonia Solani: Ascorbic acid and sclerotial differentiation. Plant Pathol. 2001, 50, 594–600. [Google Scholar] [CrossRef]
- Abkhoo, J.; Panjehkeh, N. Evaluation of antifungal activity of silver nanoparticles on Fusarium oxysporum. Int. J. Infect. 2017, 4, e41126. [Google Scholar] [CrossRef]
- Salem, M.F.; Abd-Elraoof, W.A.; Tayel, A.A.; Alzuaibr, F.M.; Abonama , O.M. Antifungal application of biosynthesized selenium nanoparticles with pomegranate peels and nanochitosan as edible coatings for citrus green mold protection. J. Nanobiotechnol. 2022, 20, 182. [Google Scholar] [CrossRef]
- Gunti, L.; Dass, R.S.; Kalagatur, N.K. Phytofabrication of Selenium Nanoparticles From Emblica officinalis Fruit Extract and Exploring Its Biopotential Applications: Antioxidant, Antimicrobial, and Biocompatibility. Front. Microbiol. 2019, 10, 931. [Google Scholar] [CrossRef]
- Shah, M.; Fawcett, D.; Sharma, S.; Tripathy, S.K.; Poinern, G.E.J. Green Synthesis of Metallic Nanoparticles via Biological Entities. Materials 2015, 8, 7278–7308. [Google Scholar] [CrossRef]
- Naqvi, Q.-A.; Kanwal, A.; Qaseem, S.; Naeem, M.; Ali, S.R.; Shaffique, M.; Maqbool, M. Size-Dependent Inhibition of Bacterial Growth by Chemically Engineered Spherical ZnO Nanoparticles. J. Biol. Phys. 2019, 45, 147–159. [Google Scholar] [CrossRef] [PubMed]
- Bisht, N.; Phalswal, P.; Khanna, P.K. Selenium Nanoparticles: A Review on Synthesis and Biomedical Applications. Mater. Adv. 2022, 3, 1415–1431. [Google Scholar] [CrossRef]
- Troni, E.; Beccari, G.; D’Amato, R.; Tini, F.; Baldo, D.; Senatore, M.T.; Beone, G.M.; Fontanella, M.C.; Prodi, A.; Businelli, D.; et al. In Vitro Evaluation of the Inhibitory Activity of Different Selenium Chemical Forms on the Growth of a Fusarium proliferatum Strain Isolated from Rice Seedlings. Plants 2021, 10, 1725. [Google Scholar] [CrossRef] [PubMed]
- Silva, M. de C.S. da; Luz, J.M.R. da; Paiva, A.P.S.; Mendes, D.R.; Carvalho, A.A.C.; Naozuka, J.; Kasuya, M.C.M. Growth and Tolerance of Pleurotus ostreatus at Different Selenium Forms. J. Agric. Sci. 2019, 11, 151. [Google Scholar] [CrossRef]
- Hu, D.; Yu, S.; Yu, D.; Liu, N.; Tang, Y.; Fan, Y.; Wang, C.; Wu, A. Biogenic Trichoderma harzianum-derived selenium nanoparticles with control functionalities originating from diverse recognition metabolites against phytopathogens and mycotoxins. Food Control. 2019, 106, 106748. [Google Scholar] [CrossRef]

| Pathogenic Microorganism | Plant Extracts | Positive Control | ||
|---|---|---|---|---|
| AGL | COF 1 | BEN | GEN/CIP 2 | |
| F. oxysporum | 0.00 | 0.00 | 6.49 + 0.34 | - |
| C. gloeosporioides | 0.00 | 0.00 | 5.29 + 0.17 | - |
| C. cladosporioides | 9.32 ± 0.23 | 0.00 | 7.18 ± 0.18 | - |
| S. marcescens | 9.24 ± 0.23 | 6.14 ± 0.15 | - | 9.23 ± 0.23 |
| A. faecalis | 9.74 ± 0.24 | 0.00 | - | 10.08 ± 0.25 |
| E. cloacae | 9.49 ± 0.23 | 0.00 | - | 9.80 ± 0.24 |
| Nanoparticles | Plant Source | Plant Tissue | Reducing Agent | Stabilizing Agent | Size (nm) |
|---|---|---|---|---|---|
| SeNPs-AGL | A. glaucum | Leaves | Leaves extracts | Leaves extracts | 8.08 |
| SeNPs-COF | C. officinalis | Flowers | Ascorbic acid | Flower extracts | 133.98 |
| Chemical Formula | SeNPs-AGL | SeNPs-COF | ||
|---|---|---|---|---|
| Mass (%) | Mol (%) | Mass (%) | Mol (%) | |
| Se | 31.27 | 8.13 | 19.11 | 4.03 |
| C | 24.39 | 41.71 | 46.68 | 64.71 |
| O | 27.49 | 35.29 | 21.43 | 22.30 |
| Na | 16.05 | 14.34 | 11.73 | 8.49 |
| Si | 0.52 | 0.38 | - | - |
| Cl | - | - | 0.49 | 0.23 |
| K | 0.29 | 0.15 | 0.56 | 0.24 |
| Total | 100.00 | 100.00 | 100.00 | 100.00 |
| Pathogenic Fungi | Propagule | Concentration | Benomyl Concentration (mg/mL) |
|---|---|---|---|
| F. oxysporum | Conidia | 1 × 105 | 35 |
| C. gloeosporioides | Conidia | 1 × 104 | 35 |
| C. cladosporioides | Conidia | 5 × 104 | 20 |
Disclaimer/Publisher’s Note: The statements, opinions and data contained in all publications are solely those of the individual author(s) and contributor(s) and not of MDPI and/or the editor(s). MDPI and/or the editor(s) disclaim responsibility for any injury to people or property resulting from any ideas, methods, instructions or products referred to in the content. |
© 2023 by the authors. Licensee MDPI, Basel, Switzerland. This article is an open access article distributed under the terms and conditions of the Creative Commons Attribution (CC BY) license (https://creativecommons.org/licenses/by/4.0/).
Share and Cite
Lazcano-Ramírez, H.G.; Garza-García, J.J.O.; Hernández-Díaz, J.A.; León-Morales, J.M.; Macías-Sandoval, A.S.; García-Morales, S. Antifungal Activity of Selenium Nanoparticles Obtained by Plant-Mediated Synthesis. Antibiotics 2023, 12, 115. https://doi.org/10.3390/antibiotics12010115
Lazcano-Ramírez HG, Garza-García JJO, Hernández-Díaz JA, León-Morales JM, Macías-Sandoval AS, García-Morales S. Antifungal Activity of Selenium Nanoparticles Obtained by Plant-Mediated Synthesis. Antibiotics. 2023; 12(1):115. https://doi.org/10.3390/antibiotics12010115
Chicago/Turabian StyleLazcano-Ramírez, Hugo Gerardo, Jorge J. O. Garza-García, José A. Hernández-Díaz, Janet M. León-Morales, Alejandro S. Macías-Sandoval, and Soledad García-Morales. 2023. "Antifungal Activity of Selenium Nanoparticles Obtained by Plant-Mediated Synthesis" Antibiotics 12, no. 1: 115. https://doi.org/10.3390/antibiotics12010115
APA StyleLazcano-Ramírez, H. G., Garza-García, J. J. O., Hernández-Díaz, J. A., León-Morales, J. M., Macías-Sandoval, A. S., & García-Morales, S. (2023). Antifungal Activity of Selenium Nanoparticles Obtained by Plant-Mediated Synthesis. Antibiotics, 12(1), 115. https://doi.org/10.3390/antibiotics12010115

